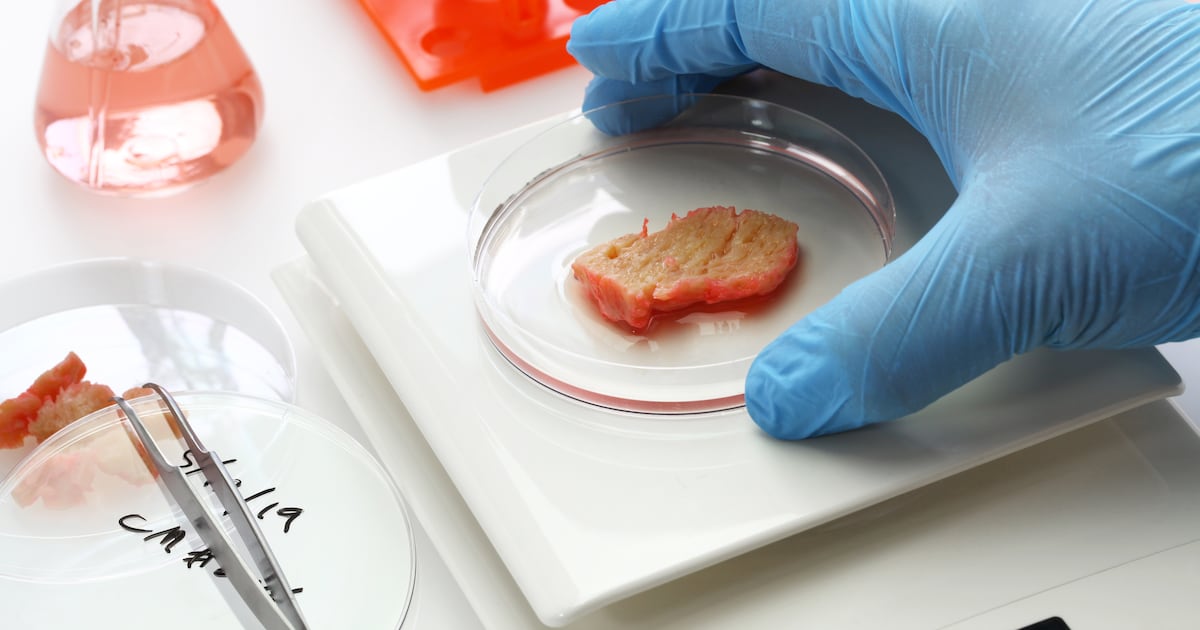
"소는 누가 키워? 세포가 키우지"...SK·한화·대상, 배양육에 꽂혔다 - 뉴스 썸네일 이미지

| 임원 | 최초 등기 | 최근 등기 | 전체 등기 소속 |
|---|---|---|---|
![]() 한국∙만 ??세 | 대표이사 2023-03-31 | ![]() 다나그린 대표이사 | |
![]() 한국∙만 ??세 | 사내이사 2023-03-31 | ![]() 다나그린 사내이사 | |
![]() 한국∙만 ??세 | 기타비상무이사 2024-06-13 | ![]() 다나그린 기타비상무이사![]() 프로 플랜 필요 | |
![]() 한국∙만 ??세 | 사내이사 2025-03-31 | ![]() 다나그린 사내이사 | |
![]() 한국∙만 ??세 | 사내이사 2025-04-14 | ![]() 다나그린 사내이사 |
기업 개요
홈페이지 주식회사 다나그린(DaNAgreen)은 2017년 7월에 설립된 한국계∙스타트업입니다.
바이오/의료∙연구/실험 분야의 프로티넷이 주요 제품/서비스입니다.
본사는 한국∙서울특별시에 위치해있습니다. 현재 대표자는 김기우입니다.
유사 기업은 큐리오칩스∙랩스피너∙엠엑스티바이오텍∙바이오스페로 등이 있습니다.

연관 키워드
최근 뉴스
- [경북테크노파크 소식] 2025 APEC 국가기술사업대전 G-TECH CONNECT 개최
- [경북 24시] 경북TP, 싱가포르서 세포배양식품 규제자유특구 알려
- 경북TP, '2025 싱가포르 농식품주간'에서 경북 세포배양식품 규제자유특...
- 의성, '도축 없는 식탁' 앞당긴다...세포배양식품 산업 글로벌 중심으로...
두 원이 겹쳐진 영역을 반복해서 누르면 가려진 원이 선택됩니다.



리드
- 1

- 2

- 3

- 1

- 2

- 3

- 1

- 2

- 3

* R&D 타임라인은 통합 과제 중 종료일 기준으로 최신 과제 일부만을 표시합니다.

프로티넷
혈청유래 단백질 기반 지지체 개발로 장기 유사체,배양육,세포치료제 분야에 적용 가능한 3차원 세포배양 키트
* 과거 회사명부터 지금 회사명까지의 인원 변동을 확인할 수 있습니다.
* 본점, 지점의 고용 데이터를 합산하여 산출한 결과입니다.
| 회사 | 제품/서비스 | 기술 | 분야 | 투자 유치 |
|---|---|---|---|---|
현재 ![]() 다나그린 한국∙스타트업 | ![]() 프로티넷 혈청유래 단백질 기반 지지체 개발로 장기 유사체,배양육,세포치료제 분야에 적용 가능한 3차원 세포배양 키트 | 연구개발 | 바이오/의료 연구/실험 | Series A 알 수 없음 |
![]() 혈관 종양-칩 혈관 네트워크 구조를 가진 종양미세환경을 구현한 칩 | 연구개발 | 바이오/의료 연구/실험 | Series A 70억원 | |
![]() 100% 자동화 엑소좀 분리기기 렙온어칩을 활용한 순도 높은 엑소좀의 효율적인 분리기술을 바탕으로 액체생검을 위한 100% 자동 엑소좀 분리기기 | 연구개발 | 바이오/의료 연구/실험 | Seed 2억원 | |
![]() 유체천공기(Hydroporator®) RUO 미세유체 기반 차세대 유전자 전달 장비 | 연구개발 | 바이오/의료 연구/실험 | Series A 55억원 | |
![]() 인간장기모사칩 인간 장기와 구조 및 기능이 비슷한 생체 칩 | 연구개발 | 바이오/의료 연구/실험 | Pre-A 12억원 | |
![]() 세포칩 세포 독성 평가를 위한 세포 칩(전극 어레이 칩) | 연구개발 | 바이오/의료 연구/실험 | Pre-A 28억 6600만원 | |
76% ![]() 케이셀바이오사이언스 한국∙스타트업 | ![]() 세포 배양 배지 세포 배양 배지 | 연구개발 | 바이오/의료 연구/실험 | Series A 105억원 |

























![[인터뷰] 김주수 의성군수 11년 전환의 기록..."소멸 위기서 미래산업 거... - 뉴스 썸네일 이미지](https://cdn.kyongbuk.co.kr/news/photo/202509/4051100_770793_5743.jpg)